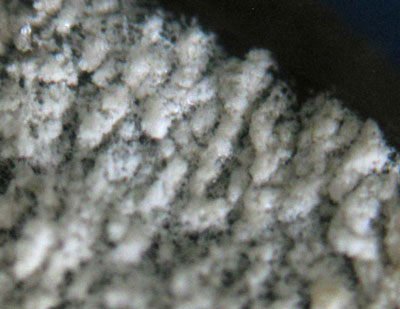

Aleurodiscus aurantius-bramenmeelschijfje Aleurodiscus aurantius-bramenmeelschijfje |
 Amphinema byssoides-harige vlieszwam Amphinema byssoides-harige vlieszwam |
 Asterostroma laxum-gladsporig sterrenkorstje Asterostroma laxum-gladsporig sterrenkorstje |
 Athelia arachnoidea-tweesporig vliesje Athelia arachnoidea-tweesporig vliesje |
 Athelia neuhoffi-kortsporig gespenvliesje Athelia neuhoffi-kortsporig gespenvliesje |
 Athelia salicum-wilgenvliesje Athelia salicum-wilgenvliesje |
 Basidioradulum radula-foptandzwam Basidioradulum radula-foptandzwam |
 Boidinia furfuracea-reageerkorstje Boidinia furfuracea-reageerkorstje |
 Botryobasidium subcoronatums-gespentrosvlies Botryobasidium subcoronatums-gespentrosvlies |
 Brevicellicium olivascens-grauwgeel dwergkorstje Brevicellicium olivascens-grauwgeel dwergkorstje |
 Bulbillomyces farinosus-korreltjeszwam Bulbillomyces farinosus-korreltjeszwam |
 Byssomerulius corium-papierzwammetje Byssomerulius corium-papierzwammetje |
 Ceraceomyces crispatus-aderig wasvlies Ceraceomyces crispatus-aderig wasvlies |
 Chondrostereum purpureum-paarse korstzwam Chondrostereum purpureum-paarse korstzwam |
 Coniophora arida-dunne kelderzwam Coniophora arida-dunne kelderzwam |
 Coniophora olivacea-harige Kelderzwam Coniophora olivacea-harige Kelderzwam |
 Coniophora puteana-dikke kelderzwam Coniophora puteana-dikke kelderzwam |
 Cotylidia undulata-franjekorsttrechtertje Cotylidia undulata-franjekorsttrechtertje |
 Cylindrobasidium laeve-donzige korstzwam Cylindrobasidium laeve-donzige korstzwam |
 Dacryobolus karstenii-papilkorstzwam Dacryobolus karstenii-papilkorstzwam |
 Dacryobolus sudans-harstandzwam Dacryobolus sudans-harstandzwam |
 Dentipellis fragilis-zachte stoppelbaardzwam Dentipellis fragilis-zachte stoppelbaardzwam |
 Dichostereum effuscatum-geweicelkorstzwam Dichostereum effuscatum-geweicelkorstzwam |
 Gyrodontium sacchari Gyrodontium sacchari |
 Hymenochaete rubiginosa-roestkleurige borstelzwam Hymenochaete rubiginosa-roestkleurige borstelzwam |
 Hyphoderma argillaceum-fijnharig harskorstje Hyphoderma argillaceum-fijnharig harskorstje |
 Hyphoderma occidentale-dun harskorstje Hyphoderma occidentale-dun harskorstje |
 Hyphoderma setigerum-barstend harskorstje Hyphoderma setigerum-barstend harskorstje |
 Hyphodontia arguta-priemtandjeszwam Hyphodontia arguta-priemtandjeszwam |
 Hyphodontia barba-jovis-franjetandjeszwam Hyphodontia barba-jovis-franjetandjeszwam |
 Hyphodontia breviseta-naaldhouttandjeszwam Hyphodontia breviseta-naaldhouttandjeszwam |
 Hyphodontia crustosa-korrelige tandjeszwam Hyphodontia crustosa-korrelige tandjeszwam |
 Hyphodontia nespori-penseeltandjeszwam Hyphodontia nespori-penseeltandjeszwam |
 Hyphodontia sambuci-witte vlierschorszwam Hyphodontia sambuci-witte vlierschorszwam |
 Hypochnicium bombycinum-harlekijnkorstje Hypochnicium bombycinum-harlekijnkorstje |
 Laxitextum bicolor-tweekleurige korstzwam Laxitextum bicolor-tweekleurige korstzwam |
 Leucogyrophana pseudomollusca Leucogyrophana pseudomollusca |
 Leucogyrophana romellii-weke aderzwam Leucogyrophana romellii-weke aderzwam |
 Limonomyces roseipellis-Roze graskorstje Limonomyces roseipellis-Roze graskorstje |
 Megalocystidium leucoxanthum-grootsporige melkkorstzwam Megalocystidium leucoxanthum-grootsporige melkkorstzwam |
 Meruliopsis taxicola-rode plakkaatzwam Meruliopsis taxicola-rode plakkaatzwam |
 Mycoacia aurea-bleke stekelkorstzwam Mycoacia aurea-bleke stekelkorstzwam |
 Mycoacia fuscoatra-bruinzwarte stekelkorstzwam Mycoacia fuscoatra-bruinzwarte stekelkorstzwam |
 Mycoacia uda-gele stekelkorstzwam Mycoacia uda-gele stekelkorstzwam |
 Peniophora aurantiaca Peniophora aurantiaca |
 Peniophora incarnata-oranjerode schorszwam Peniophora incarnata-oranjerode schorszwam |
 Peniophora limitata-essenschorszwam Peniophora limitata-essenschorszwam |
 Peniophora lycii-berijpte schorszwam Peniophora lycii-berijpte schorszwam |
 Peniophora polygonia-roze populierenschorszwam Peniophora polygonia-roze populierenschorszwam |
 Peniophorella pubera-fluwelig harskorstje Peniophorella pubera-fluwelig harskorstje |
 Peniophora quercina-paarse Eikenschorszwam Peniophora quercina-paarse Eikenschorszwam |
 Peniophora rufomarginata-lindeschorszwam Peniophora rufomarginata-lindeschorszwam |
 Phanerochaete filamentosa-karamelhuidje Phanerochaete filamentosa-karamelhuidje |
 Phanerochaete laevis-gebarsten huidje Phanerochaete laevis-gebarsten huidje |
 Phanerochaete sordida-groezelig huidje Phanerochaete sordida-groezelig huidje |
 Phanerochaete velutina-ruig huidje Phanerochaete velutina-ruig huidje |
 Phlebia ochraceofulva-okerbruine aderzwam Phlebia ochraceofulva-okerbruine aderzwam |
 Phlebia radiata-oranje aderzwam Phlebia radiata-oranje aderzwam |
 Phlebia rufa-porieaderzwam Phlebia rufa-porieaderzwam |
 Phlebia tremellosa-spekzwoerdzwam Phlebia tremellosa-spekzwoerdzwam |
 Phlebiella fibrillosa-rafelig wasje Phlebiella fibrillosa-rafelig wasje |
 Phlebiella vaga-zwavelschorszwam Phlebiella vaga-zwavelschorszwam |
 Phlebiopsis gigantea-dennenharszwam Phlebiopsis gigantea-dennenharszwam |
 Phlebiopsis ravenelii-loofhoutharszwam Phlebiopsis ravenelii-loofhoutharszwam |
 Piloderma byssinum-wit franjevlies Piloderma byssinum-wit franjevlies |
 Porogramme albocincta Porogramme albocincta |
 Porostereum spadiceum-leerachtige korstzwam Porostereum spadiceum-leerachtige korstzwam |
 Pseudochaete tabacina-tabakborstelzwam Pseudochaete tabacina-tabakborstelzwam |
 Radulomyces confluens-ziekenhuisboomkorst Radulomyces confluens-ziekenhuisboomkorst |
 Radulomyces hiemalis-mammoetboomkorst Radulomyces hiemalis-mammoetboomkorst |
 Radulomyces molaris-getande boomkorst Radulomyces molaris-getande boomkorst |
 Schizopora paradoxa-witte tandzwam Schizopora paradoxa-witte tandzwam |
 Schizopora radula-splijtende tandzwam Schizopora radula-splijtende tandzwam |
 Scopuloides hydnoides-wastandjeszwam Scopuloides hydnoides-wastandjeszwam |
 Scytinostroma hemidichophyticum-rondsporige stinkkorstzwam Scytinostroma hemidichophyticum-rondsporige stinkkorstzwam |
 Serpula himantioides-dakloze huiszwam Serpula himantioides-dakloze huiszwam |
 Steccherinum bourdotii-grootsporige raspzwam Steccherinum bourdotii-grootsporige raspzwam |
 Steccherinum fimbriatum-geveerde raspzwam Steccherinum fimbriatum-geveerde raspzwam |
 Steccherinum ochraceum-roze raspzwam Steccherinum ochraceum-roze raspzwam |
 Stereum gausapatum-eikenbloedzwam Stereum gausapatum-eikenbloedzwam |
 Stereum hirsutum-gele korstzwam Stereum hirsutum-gele korstzwam |
 Stereum ochraceoflavum-twijgkorstzwam Stereum ochraceoflavum-twijgkorstzwam |
 Stereum rugosum-gerimpelde korstzwam Stereum rugosum-gerimpelde korstzwam |
 Stereum sanguinolentum-dennenbloedzwam Stereum sanguinolentum-dennenbloedzwam |
 Stereum subtomentosum-waaierkorstzwam Stereum subtomentosum-waaierkorstzwam |
 Terana coerulea-blauwe korstzwam Terana coerulea-blauwe korstzwam |
 Thelephora anthocephala-gespleten franjezwam Thelephora anthocephala-gespleten franjezwam |
 Thelephora caryophyllea-prachtfranjezwam Thelephora caryophyllea-prachtfranjezwam |
 Thelephora palmata-stinkende franjezwam Thelephora palmata-stinkende franjezwam |
 Thelephora penicillata-penseelfranjezwam Thelephora penicillata-penseelfranjezwam |
 Thelephora terrestris-gewone franjezwam Thelephora terrestris-gewone franjezwam |
 Tomentella badia-bruin rouwkorstje Tomentella badia-bruin rouwkorstje |
 Tomentella fuscocinerea-gesploos rouwkorstje Tomentella fuscocinerea-gesploos rouwkorstje |
 Tomentella sublilacina-gewoon rouwkorstje Tomentella sublilacina-gewoon rouwkorstje |
 Trechispora cohaerens-gladsporig dwergkorstje Trechispora cohaerens-gladsporig dwergkorstje |
 Trechispora farinacea-melig dwergkorstje Trechispora farinacea-melig dwergkorstje |
 Trechispora fastidiosa-stinkdwergkorstje Trechispora fastidiosa-stinkdwergkorstje |
 Trechispora mollusca-raatzwammetje Trechispora mollusca-raatzwammetje |
 Trechispora nivea-pegeldwergkorstje Trechispora nivea-pegeldwergkorstje |
 Tubulicrinis accedens-glitterend oploskorstje Tubulicrinis accedens-glitterend oploskorstje |
 Tubulicrinis medius-borstelig oploskorstje Tubulicrinis medius-borstelig oploskorstje |
 Vuilleminia comedens-gewone schorsbreker Vuilleminia comedens-gewone schorsbreker |
 Vuilleminia coryli-hazelaarschorsbreker Vuilleminia coryli-hazelaarschorsbreker |
 Amphinema byssoides-harige vlieszwam
Amphinema byssoides-harige vlieszwam Asterostroma laxum-gladsporig sterrenkorstje
Asterostroma laxum-gladsporig sterrenkorstje Athelia arachnoidea-tweesporig vliesje
Athelia arachnoidea-tweesporig vliesje Athelia neuhoffi-kortsporig gespenvliesje
Athelia neuhoffi-kortsporig gespenvliesje Athelia salicum-wilgenvliesje
Athelia salicum-wilgenvliesje Basidioradulum radula-foptandzwam
Basidioradulum radula-foptandzwam Boidinia furfuracea-reageerkorstje
Boidinia furfuracea-reageerkorstje Botryobasidium subcoronatums-gespentrosvlies
Botryobasidium subcoronatums-gespentrosvlies Brevicellicium olivascens-grauwgeel dwergkorstje
Brevicellicium olivascens-grauwgeel dwergkorstje Bulbillomyces farinosus-korreltjeszwam
Bulbillomyces farinosus-korreltjeszwam Byssomerulius corium-papierzwammetje
Byssomerulius corium-papierzwammetje Ceraceomyces crispatus-aderig wasvlies
Ceraceomyces crispatus-aderig wasvlies Chondrostereum purpureum-paarse korstzwam
Chondrostereum purpureum-paarse korstzwam Coniophora arida-dunne kelderzwam
Coniophora arida-dunne kelderzwam Coniophora olivacea-harige Kelderzwam
Coniophora olivacea-harige Kelderzwam Coniophora puteana-dikke kelderzwam
Coniophora puteana-dikke kelderzwam Cotylidia undulata-franjekorsttrechtertje
Cotylidia undulata-franjekorsttrechtertje Cylindrobasidium laeve-donzige korstzwam
Cylindrobasidium laeve-donzige korstzwam Dacryobolus karstenii-papilkorstzwam
Dacryobolus karstenii-papilkorstzwam Dacryobolus sudans-harstandzwam
Dacryobolus sudans-harstandzwam Dentipellis fragilis-zachte stoppelbaardzwam
Dentipellis fragilis-zachte stoppelbaardzwam Dichostereum effuscatum-geweicelkorstzwam
Dichostereum effuscatum-geweicelkorstzwam Gyrodontium sacchari
Gyrodontium sacchari Hymenochaete rubiginosa-roestkleurige borstelzwam
Hymenochaete rubiginosa-roestkleurige borstelzwam Hyphoderma argillaceum-fijnharig harskorstje
Hyphoderma argillaceum-fijnharig harskorstje Hyphoderma occidentale-dun harskorstje
Hyphoderma occidentale-dun harskorstje Hyphoderma setigerum-barstend harskorstje
Hyphoderma setigerum-barstend harskorstje Hyphodontia arguta-priemtandjeszwam
Hyphodontia arguta-priemtandjeszwam Hyphodontia barba-jovis-franjetandjeszwam
Hyphodontia barba-jovis-franjetandjeszwam Hyphodontia breviseta-naaldhouttandjeszwam
Hyphodontia breviseta-naaldhouttandjeszwam Hyphodontia crustosa-korrelige tandjeszwam
Hyphodontia crustosa-korrelige tandjeszwam Hyphodontia nespori-penseeltandjeszwam
Hyphodontia nespori-penseeltandjeszwam Hyphodontia sambuci-witte vlierschorszwam
Hyphodontia sambuci-witte vlierschorszwam Hypochnicium bombycinum-harlekijnkorstje
Hypochnicium bombycinum-harlekijnkorstje Laxitextum bicolor-tweekleurige korstzwam
Laxitextum bicolor-tweekleurige korstzwam Leucogyrophana pseudomollusca
Leucogyrophana pseudomollusca Leucogyrophana romellii-weke aderzwam
Leucogyrophana romellii-weke aderzwam Limonomyces roseipellis-Roze graskorstje
Limonomyces roseipellis-Roze graskorstje Megalocystidium leucoxanthum-grootsporige melkkorstzwam
Megalocystidium leucoxanthum-grootsporige melkkorstzwam Meruliopsis taxicola-rode plakkaatzwam
Meruliopsis taxicola-rode plakkaatzwam Mycoacia aurea-bleke stekelkorstzwam
Mycoacia aurea-bleke stekelkorstzwam Mycoacia fuscoatra-bruinzwarte stekelkorstzwam
Mycoacia fuscoatra-bruinzwarte stekelkorstzwam Mycoacia uda-gele stekelkorstzwam
Mycoacia uda-gele stekelkorstzwam Peniophora aurantiaca
Peniophora aurantiaca Peniophora incarnata-oranjerode schorszwam
Peniophora incarnata-oranjerode schorszwam Peniophora limitata-essenschorszwam
Peniophora limitata-essenschorszwam Peniophora lycii-berijpte schorszwam
Peniophora lycii-berijpte schorszwam Peniophora polygonia-roze populierenschorszwam
Peniophora polygonia-roze populierenschorszwam Peniophorella pubera-fluwelig harskorstje
Peniophorella pubera-fluwelig harskorstje Peniophora quercina-paarse Eikenschorszwam
Peniophora quercina-paarse Eikenschorszwam  Peniophora rufomarginata-lindeschorszwam
Peniophora rufomarginata-lindeschorszwam Phanerochaete filamentosa-karamelhuidje
Phanerochaete filamentosa-karamelhuidje Phanerochaete laevis-gebarsten huidje
Phanerochaete laevis-gebarsten huidje Phanerochaete sordida-groezelig huidje
Phanerochaete sordida-groezelig huidje Phanerochaete velutina-ruig huidje
Phanerochaete velutina-ruig huidje Phlebia ochraceofulva-okerbruine aderzwam
Phlebia ochraceofulva-okerbruine aderzwam Phlebia radiata-oranje aderzwam
Phlebia radiata-oranje aderzwam Phlebia rufa-porieaderzwam
Phlebia rufa-porieaderzwam Phlebia tremellosa-spekzwoerdzwam
Phlebia tremellosa-spekzwoerdzwam Phlebiella fibrillosa-rafelig wasje
Phlebiella fibrillosa-rafelig wasje Phlebiella vaga-zwavelschorszwam
Phlebiella vaga-zwavelschorszwam Phlebiopsis gigantea-dennenharszwam
Phlebiopsis gigantea-dennenharszwam Phlebiopsis ravenelii-loofhoutharszwam
Phlebiopsis ravenelii-loofhoutharszwam Piloderma byssinum-wit franjevlies
Piloderma byssinum-wit franjevlies Porogramme albocincta
Porogramme albocincta Porostereum spadiceum-leerachtige korstzwam
Porostereum spadiceum-leerachtige korstzwam Pseudochaete tabacina-tabakborstelzwam
Pseudochaete tabacina-tabakborstelzwam Radulomyces confluens-ziekenhuisboomkorst
Radulomyces confluens-ziekenhuisboomkorst Radulomyces hiemalis-mammoetboomkorst
Radulomyces hiemalis-mammoetboomkorst Radulomyces molaris-getande boomkorst
Radulomyces molaris-getande boomkorst Schizopora paradoxa-witte tandzwam
Schizopora paradoxa-witte tandzwam Schizopora radula-splijtende tandzwam
Schizopora radula-splijtende tandzwam Scopuloides hydnoides-wastandjeszwam
Scopuloides hydnoides-wastandjeszwam Scytinostroma hemidichophyticum-rondsporige stinkkorstzwam
Scytinostroma hemidichophyticum-rondsporige stinkkorstzwam Serpula himantioides-dakloze huiszwam
Serpula himantioides-dakloze huiszwam Steccherinum bourdotii-grootsporige raspzwam
Steccherinum bourdotii-grootsporige raspzwam Steccherinum fimbriatum-geveerde raspzwam
Steccherinum fimbriatum-geveerde raspzwam Steccherinum ochraceum-roze raspzwam
Steccherinum ochraceum-roze raspzwam Stereum gausapatum-eikenbloedzwam
Stereum gausapatum-eikenbloedzwam Stereum hirsutum-gele korstzwam
Stereum hirsutum-gele korstzwam Stereum ochraceoflavum-twijgkorstzwam
Stereum ochraceoflavum-twijgkorstzwam Stereum rugosum-gerimpelde korstzwam
Stereum rugosum-gerimpelde korstzwam Stereum sanguinolentum-dennenbloedzwam
Stereum sanguinolentum-dennenbloedzwam Stereum subtomentosum-waaierkorstzwam
Stereum subtomentosum-waaierkorstzwam Terana coerulea-blauwe korstzwam
Terana coerulea-blauwe korstzwam Thelephora anthocephala-gespleten franjezwam
Thelephora anthocephala-gespleten franjezwam Thelephora caryophyllea-prachtfranjezwam
Thelephora caryophyllea-prachtfranjezwam Thelephora palmata-stinkende franjezwam
Thelephora palmata-stinkende franjezwam Thelephora penicillata-penseelfranjezwam
Thelephora penicillata-penseelfranjezwam Thelephora terrestris-gewone franjezwam
Thelephora terrestris-gewone franjezwam Tomentella badia-bruin rouwkorstje
Tomentella badia-bruin rouwkorstje Tomentella fuscocinerea-gesploos rouwkorstje
Tomentella fuscocinerea-gesploos rouwkorstje Tomentella sublilacina-gewoon rouwkorstje
Tomentella sublilacina-gewoon rouwkorstje Trechispora cohaerens-gladsporig dwergkorstje
Trechispora cohaerens-gladsporig dwergkorstje Trechispora farinacea-melig dwergkorstje
Trechispora farinacea-melig dwergkorstje Trechispora fastidiosa-stinkdwergkorstje
Trechispora fastidiosa-stinkdwergkorstje Trechispora mollusca-raatzwammetje
Trechispora mollusca-raatzwammetje Trechispora nivea-pegeldwergkorstje
Trechispora nivea-pegeldwergkorstje Tubulicrinis accedens-glitterend oploskorstje
Tubulicrinis accedens-glitterend oploskorstje Tubulicrinis medius-borstelig oploskorstje
Tubulicrinis medius-borstelig oploskorstje Vuilleminia comedens-gewone schorsbreker
Vuilleminia comedens-gewone schorsbreker Vuilleminia coryli-hazelaarschorsbreker
Vuilleminia coryli-hazelaarschorsbreker